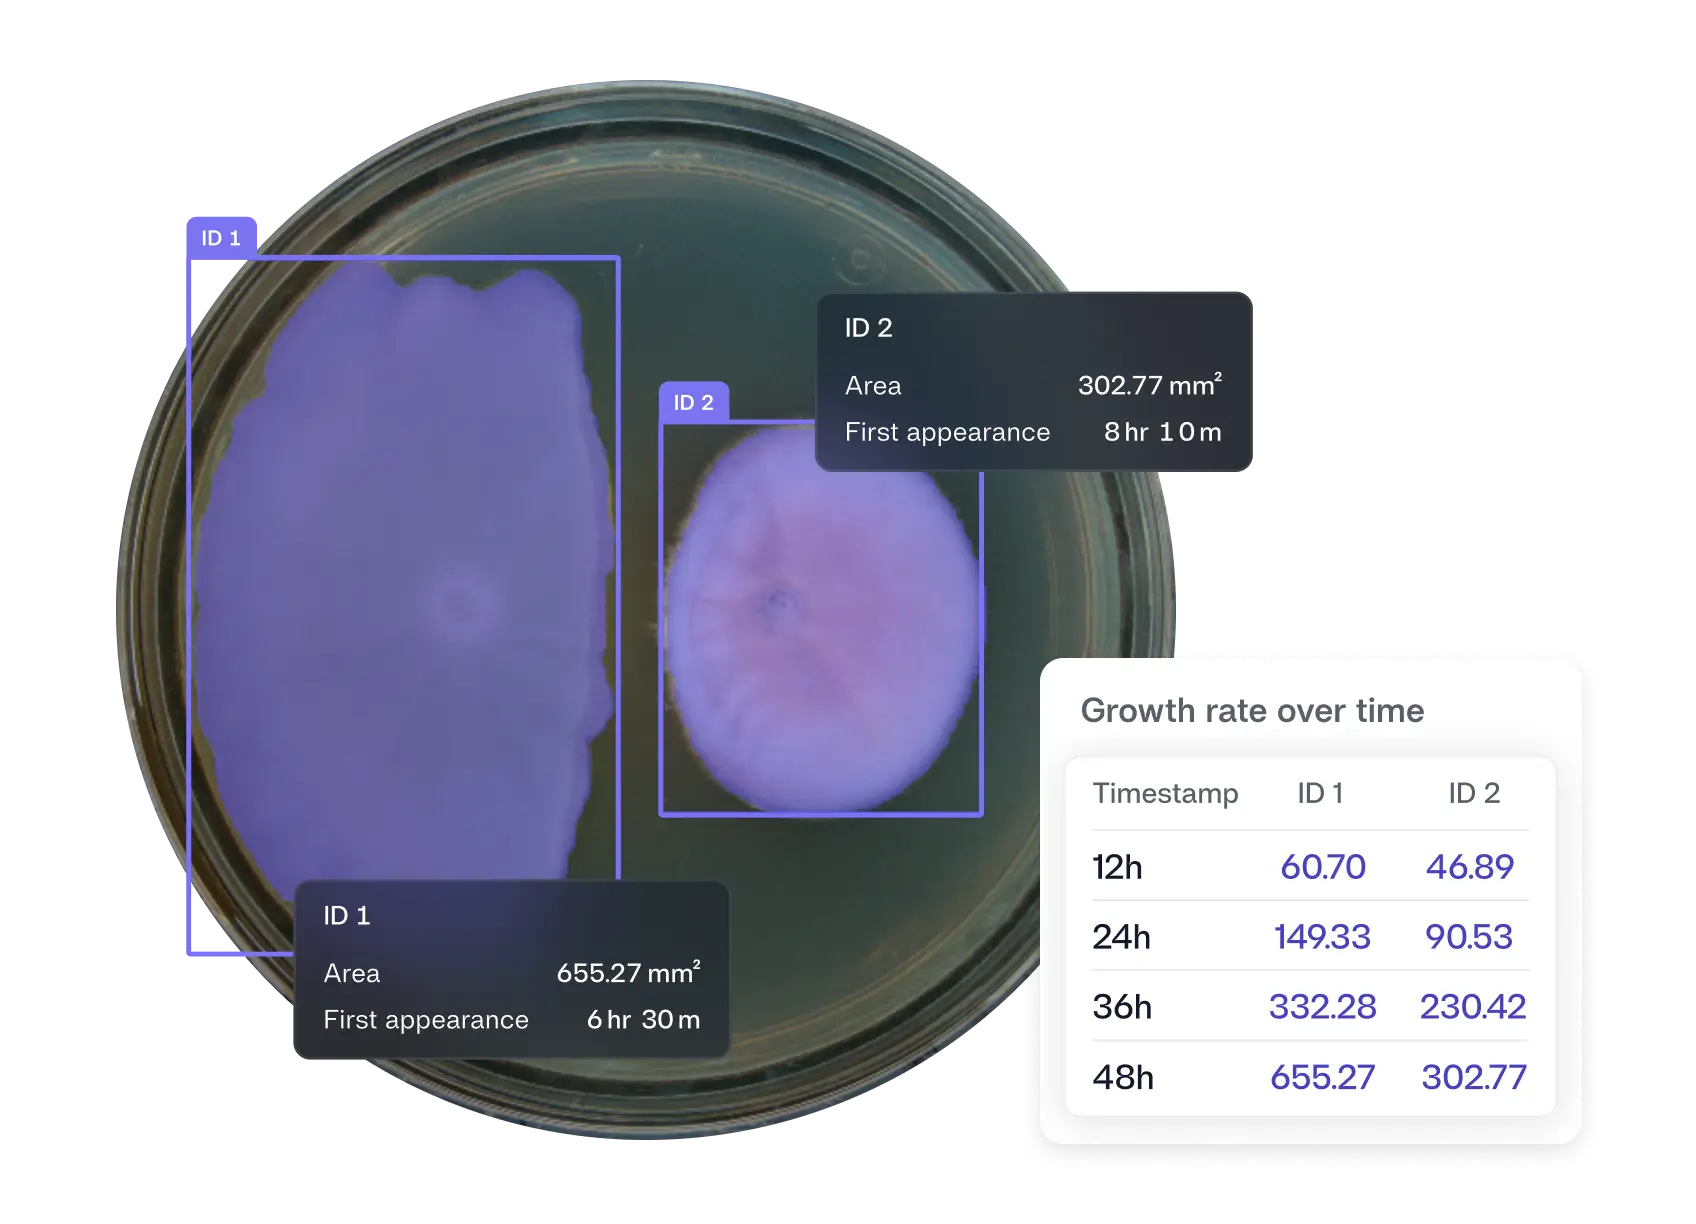
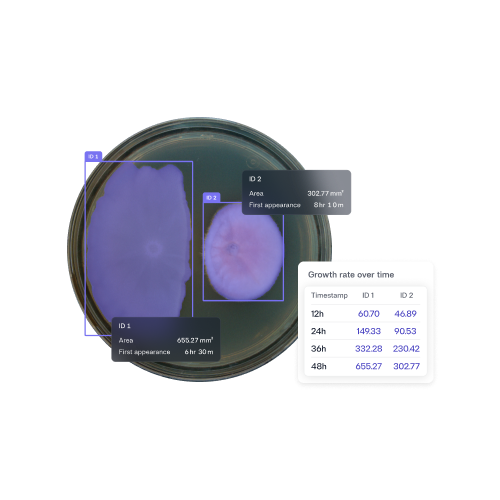
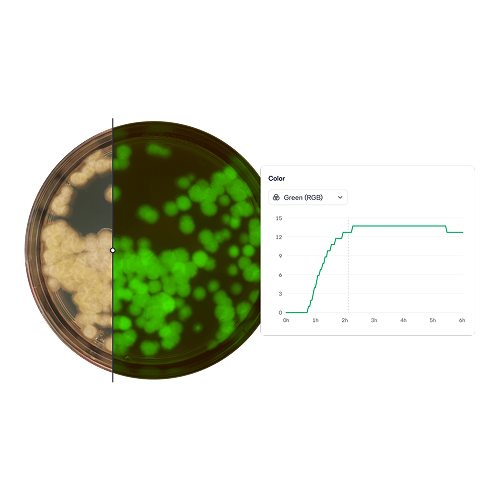

From plate design to organism insights. All in one place.
Design plates fast and consistently without spreadsheets or handwritten notes. Plate Designer helps you define plate layouts faster with clear, structured metadata that flows directly into downstream analysis.
“With the help of Reshape, we have moved further in improving the workflow in 6 months than in the 3 years before with other solutions we tried.”
“Getting deep insights into everything that happens during our experiment is hugely helpful to discover new phenomena more quickly.”
"The Reshape system has revolutionized how we screen and study microbial clones. We can now track metabolite production, release, and diffusion at an unprecedented scale.”
Fast plate mapping at scale
Unlike standard incubators, Reshape’s Smart Incubator provides continuous high-resolution imaging and precise AI analysis while your experiments incubate. It captures what would otherwise be missed—giving you an entirely new way to understand your assays.
Yes, it’s an incubator.

That can be controlled with up to five different temperatures, all at once.
But it’s also a camera.

It images all of your experiments during incubation and provides time lapse videos on our platform.
And it’s also a plate reader.

Get data such as colony counts, OD, color, size, and much more with our AI models.
Versatile plate and assay compatibility
Image any standard plate format, from Petri dishes to 384-well plates,
and run a wide range of assays.
Fits 75 petri dishes or 50 microtiter plates per incubator.
Fast plate mapping at scale
Reshape Discovery Platform
AI models that turn every assay into objective, digital data
From growth kinetics and viable counts to inhibition zones, fluorescence, and morphology, our AI models gives you results faster, with data that’s rich and reliable.
Explore DiscoveryDon’t think we can do it? Send us an image of your assay and we’ll send back a report.
Send it in
Send us a clear picture of your assay on black or white background with minimum reflections. Describe your assay, how much time you spend doing it today, and what data you want.
We’ll analyze it
Using our standard models or work discuss with our data science team how to do it.
Receive a report from us within 3 days
We’ll revert back with our findings, show you the results, and tell you how hard it was!
Fast plate mapping at scale
Whats included:
Growth lab
The perfect match for labs looking to fully digitize their experiments and experience true hands-off data capture.
Everything in Starter, plus:
Industry lab
For industry partners looking to digitize proprietary assays and integrate with LIMS systems
Everything in Growth, plus:
Enterprise
For fully custom setups, both hardware- and software wise.
Fast plate mapping at scale
Get answers to commonly asked questions.
What plate types are supported?
It is very flexible and can take anything from Petri dishes to 6–384 well microtiter plates.
How big is it?
One incubator is: Height: 190 cm (74.8 inches), Width: 88 cm (34.6 inches), Depth: 60 cm (23.6 inches).
How often can it take images?
From every 10 minutes upwards.
Can I run different assays with the same incubator?
Yes, you can run insect assays one day and colony count plates the other. The same incubator can be used for all of our assays.
How many plates can it hold?
Each incubator rack can hold 75 petri dishes or 50 microtiter plates. One sub-unit can hold up to 15 standard Petri dishes or 10 microtiter plates.
What temperature ranges are supported?
The incubators can be set between ambient +3 °C and 40 °C, covering most microbiology assays.
Does it work in dark or light conditions?
Yes, the imaging system is fully controlled and does not depend on ambient light. Optional illumination modules allow top and bottom light for dark agar and media and fluorescence imaging.
Can I access my data remotely?
All images and analysis data are stored in the Discovery platform and can be accessed through a secure web interface, making it easy to collaborate or review results from anywhere.
How easy is it to set up?
The incubators can be set between ambient +3 °C and 40 °C, covering most microbiology assays.